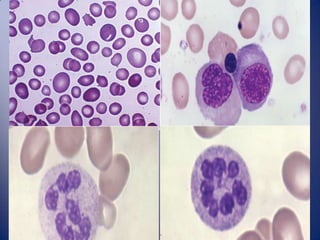

Este documento describe los roles del folato y la cobalamina en el metabolismo, así como la anemia megaloblástica causada por deficiencias de estos nutrientes. Explica que el folato y la cobalamina son necesarios para la síntesis de DNA y que su deficiencia causa una maduración anormal de los eritrocitos. También detalla los síntomas, diagnóstico y tratamiento de la anemia megaloblástica.